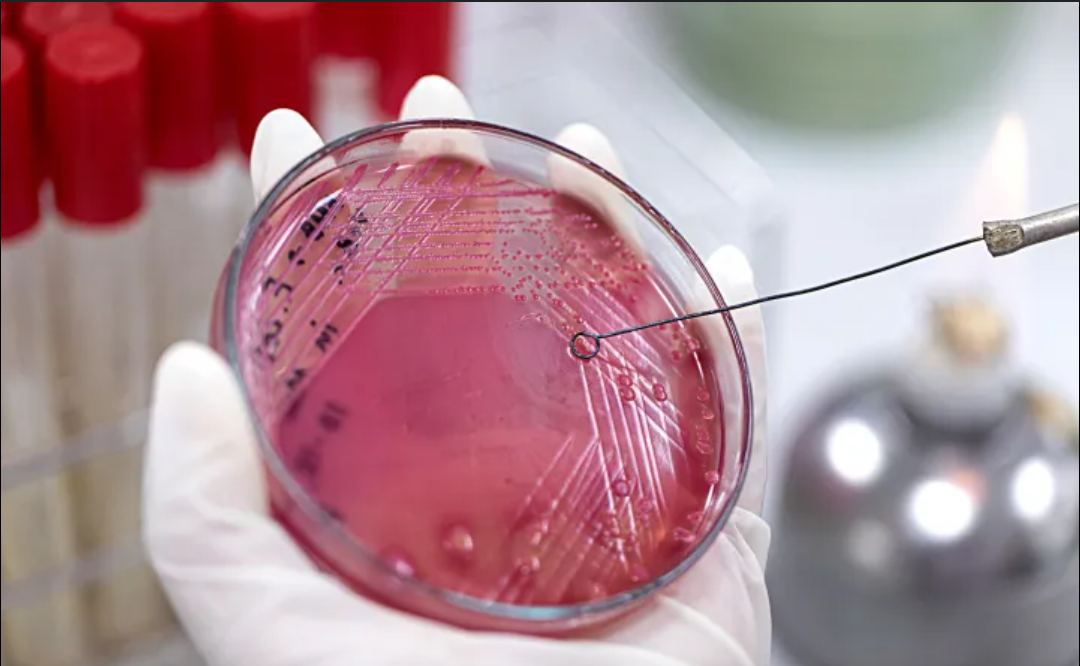
Screenshot_20241213-150145

Scientists have issued an urgent warning about lab-created ‘mirror bacteria’ with the potential to wipe out humanity
Although the capability to create organisms or bacteria that utilize mirror molecules remains at least a decade away by many estimations, 38 authors of an article published in Science Thursday said that investigation into creating such “mirror life” should not be pursued.
The authors said they “were initially skeptical that mirror bacteria could pose major risks,” but have since grown “deeply concerned.”
In humans, the left hand and the right hand are mirror images of one another, but they’re not identical. One can’t be perfectly superimposed on the other. Neither can many molecules.
The specific “handedness” of a molecule allows it to interact in particular ways to perform biological functions, much as a “left hand interacts differently with left- and right-hand gloves.”
Scientists say mirror image versions of life are possible: organisms built on molecules that, for example, don’t use the normal “right-handed” DNA of life on Earth, but a synthesized “left-handed” DNA instead.
Technological developments will eventually make it possible to synthesize mirror bacteria, the authors said, and their assessment of studies about that possibility has “led us to conclude that infections could be severe.”
Safeguards against the spread of mirror bacteria—which do not exist in nature, so humans and other animals would likely have little immunity to them—could be insufficient.
Laboratory containment could fail, as could engineering to make them unable to live outside of controlled settings.
Creating even a mirror bacterium, a single-celled organism, “would be a far more complex feat of biological engineering than has ever been accomplished,” the authors said.
But progress in disparate areas of research could make it possible. Scientists have already been able to synthesize large mirror biomolecules, including nucleic acids and proteins.
At the same time, researchers are making progress in creating cells completely from synthetic material—technology that would also make it possible to create synthetic mirror cells.
Some research suggests mirror-image molecules could be useful in the production of effective drugs, with the body less able to degrade them than the normal molecules. For similar reasons, however, mirror bacteria could pose a severe threat to humans.
For instance, the authors noted that mirror proteins do not “reliably trigger important adaptive immune responses such as the production of antibodies.”
The mirror bacteria might be able to evade the immune systems of many vertebrates, invertebrates, and plants. “Overall, we are concerned that mirror bacteria might act as serious pathogens with an unusually broad host range.”
According to The Guardian, one of the report’s authors, Kate Adamala, a synthetic biologist at the University of Minnesota, said she switched from working on mirror cells to opposing their creation.
“We should not be making mirror life,” she told the newspaper. “We have time for the conversation. And that’s what we were trying to do with this paper, to start a global conversation.”
Other authors include, among others, two Nobel laureates, as well as Harvard geneticist George Church, who is working to “de-extinct” the wooly mammoth; and Kevin Esvelt, an MIT biotechnologist who developed the CRISPR gene drive, which can propagate genetic traits in populations as it spreads.





